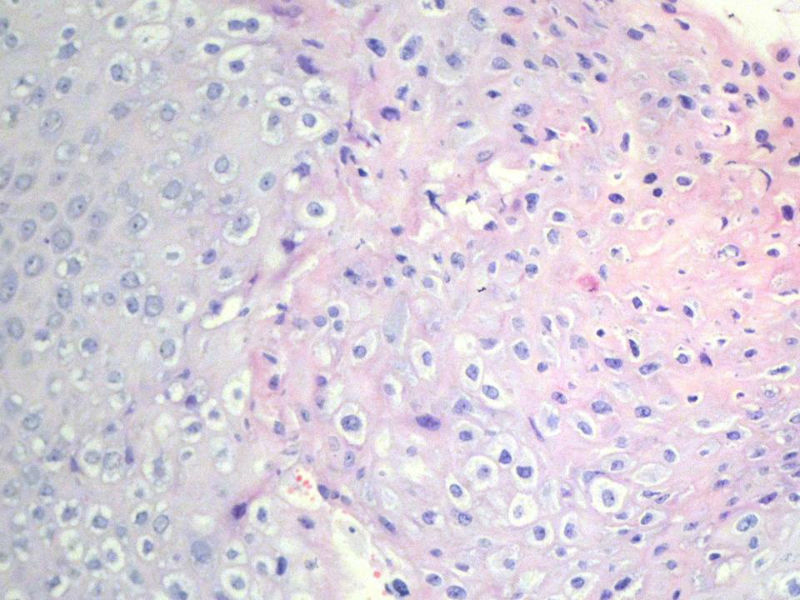
右外耳道肿物，新加免疫组化图9

| 图片: | |
|---|---|
| 名称: | |
| 描述: | |
- 右外耳道肿物,新加免疫组化
男,72岁,右耳听力下降两个月,检查右外耳道有黄豆大肿物,表面乳头状,手术切除。

名称:图1
描述:幻灯片2

名称:图2
描述:幻灯片3

名称:图3
描述:幻灯片4

名称:图4
描述:幻灯片5

名称:图5
描述:幻灯片6

名称:图6
描述:幻灯片7

名称:图7
描述:幻灯片8

名称:图8
描述:幻灯片9
名称:图9
描述:幻灯片10

名称:图10
描述:幻灯片11

名称:图11
描述:幻灯片12

名称:图12
描述:幻灯片13
标签:
-
本帖最后由 xclbljys 于 2011-11-16 20:37:15 编辑

- 许春雷
×参考诊断
-
binghongcha 离线
- 帖子:311
- 粉蓝豆:452
- 经验:334
- 注册时间:2011-08-02
- 加关注 | 发消息





























